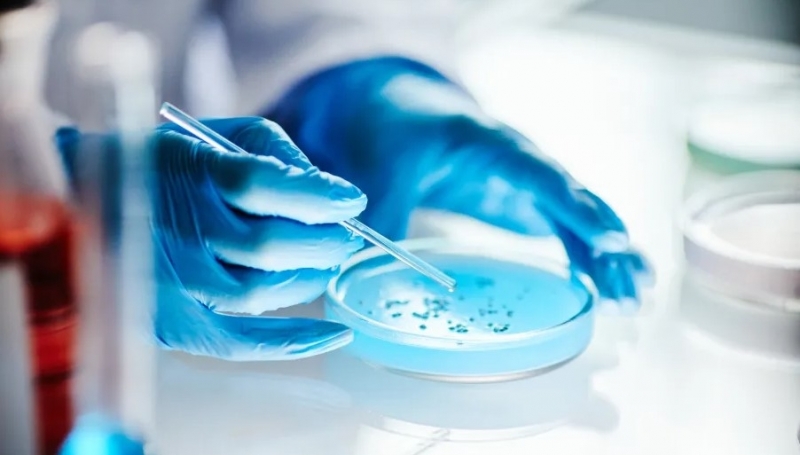

Учени успяха да неутрализират генетичната причина за синдрома на Даун
Учени успяха да неутрализират генетичната причина за синдрома на Даун в лабораторни условия, използвайки комбинация от технологията CRISPR и естествен биологичен механизъм. Така те постигат изключване на допълнителната хромозома, отговорна за състоянието, в човешки клетки.
Ежедневието на хората със синдром на Даун е съпътствано от сериозни предизвикателства - забавено развитие, когнитивни затруднения и повишен риск от ранни заболявания като Алцхаймер, пише БГНЕС. Досега медицината се ограничаваше до подкрепа на пациентите, без възможност да въздейства върху основната генетична причина.
Новото изследване обаче променя тази перспектива. В лабораториите на медицинския център „Бет Израел Дийкънес“ в Бостън екип от невролози доказва, че е възможно генетичната аномалия да бъде заглушена.
Предизвикателството е значително, тъй като за разлика от други генетични заболявания, при които е засегнат един ген, синдромът на Даун включва наличието на допълнителна хромозома. Учените намират решение, вдъхновено от природата. При жените една от двете X-хромозоми се деактивира естествено чрез гена XIST. Изследователите използват CRISPR, за да въведат този ген директно в третото копие на 21-вата хромозома в болните клетки. В резултат допълнителната хромозома се „изключва“ и спира да изпраща смущаващи сигнали към организма.
Постижението представлява сериозен пробив спрямо предишни опити. Докато по-старите методи не успяваха да обхванат достатъчно клетки, новият подход показва ефективност между 20% и 40% от изследваните клетъчни линии. Това значително повишава вероятността разработката да се превърне в реална терапия.
Водещият автор на изследването д-р Волни Шийн подчертава значението на резултатите: „Този подход позволява да се преодолее ключова пречка“, като допълва, че методът вече може да бъде мащабиран.
Процедурата е внимателно контролирана, така че да засяга само едно копие на хромозомата, без да нарушава останалите две, които са необходими за нормалното функциониране на организма. Така учените демонстрират, че хромозомната терапия вече не е научна фантастика, а реалност в лабораторни условия.
Пътят до практическо приложение остава дълъг. Следващият етап включва изследвания върху мишки, за да се установи най-подходящият момент за намеса и дали тя може да се извършва още преди раждането. Изяснява се и дали частичното изключване на допълнителната хромозома би било достатъчно за значително подобрение на когнитивните способности и общото здраве.
Паралелни изследвания показват, че дори малка част от гена XIST може да бъде ефективна, което би улеснило доставянето му до мозъчните клетки - традиционно труднодостъпни за терапия. Перспективата е тежко генетично състояние да бъде превърнато в управляемо или почти незабележимо в ежедневието.
За семействата и организациите, подкрепящи хора със синдром на Даун, новината носи силна надежда. Възможността за по-дълъг живот - средно около 60 години - и по-добро качество на живот е мощен стимул за медицинската общност. Научният подход не цели да заличи различията, а да осигури равни възможности.
Предпазливостта остава необходима, но оптимизмът е осезаем. Основите на бъдеща хромозомна терапия вече са поставени и според изследователите, публикували резултатите си в списание „Известия на Националната академия на науките на САЩ“, един ден подобни заболявания може да останат в миналото.
17.04.2026, 13:48 часа
141
0